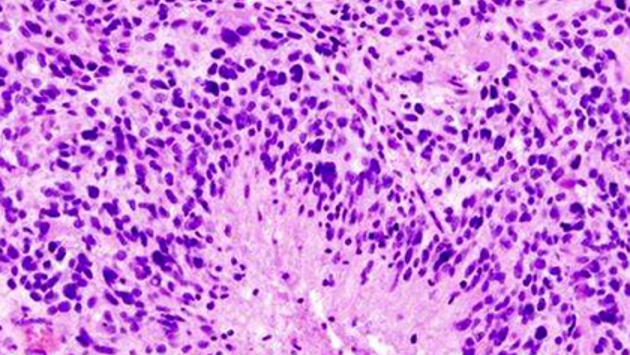

Американские ученые из Сент-Луиса (США) завершают успешное слепое рандомизированное контролируемое испытание противоопухолевой вакцины DCVax-L. Как показали предварительные результаты, новая терапия улучшила выживаемость пациентов с агрессивной глиобластомой. Об этом сообщается в пресс-релизе на сайте MedicalXpress.
В исследовании принял участие 331 пациент, который был случайным образом распределен в две группы. В первой добровольцы проходили стандартную химиотерапию с применением персонализированной вакцины, во второй химиотерапия была совмещена с плацебо. При этом, согласно протоколу испытания, тех, кто получал вакцину, было вдвое больше, чем людей в контрольной группе. Кроме того, любой мог получить вакцину, если его болезнь прогрессировала после первоначального лечения. Таким образом, исследуемое лекарство, в конечном итоге, получили 90 процентов участников.
Обычно пациенты с глиобластомой живут, в среднем, менее 18 месяцев после постановки диагноза. В ходе исследования средняя выживаемость у добровольцев составила чуть более 23 месяцев. При этом 100 пациентов дожили до 40,5 месяца. Хотя ученые пока точно не знают, кто из них действительно получал вакцину, поскольку исследование продолжается, они уверены, что продолжительность жизни увеличилась из-за DCVax-L.
Вакцина является специфичной для каждого пациента. После операции, в ходе которой удаляют значительную часть опухоли, злокачественные ткани подвергают воздействию иммунными клетками — дендритными клетками. Они поглощают антигены глиобластомы, после чего их вводят обратно больному. Лимфоциты в организме пациента распознают антиген, находящийся на поверхности дендритных клеток, и атакуют оставшиеся клетки опухоли, имеющие тот же самый антиген.
Хотя глиобластому часто называют «раком мозга», термин «рак», как правило, используется в отношении карцином, развивающихся из эпителиальной ткани различных органов. Глиобластома же возникает из-за неконтролируемого деления глии — вспомогательных клеток, окружающих нервную ткань, обеспечивающих передачу импульсов и выполняющих другие вспомогательные функции.